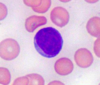
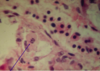

HIGHLIGHTS Flashcards
Diagnostic pathology
an AUTOPSY (syn: necropsy) may be performed to determine the cause of death in an individual or in a group of animals or to explain decreased production
Forensic pathology
the purpose of an autopsy is to determine the nature of death from a legal perspective
Surgical pathology
(histologic examination of surgically excised tissue specimens) not only facilitates diagnosis and prognosis for a living animal but also can be the basis for therapy
Experimental pathology
Contributes from the design to the endpoint of an investigation with the goal of correlating morphologic changes with clinical, functional, and biochemical parameters to elucidate the mechanisms of disease
Comparative pathology
compares specific human pathologies with those seen in natural animal models
(tuberculosis, anthrax, erysipelas etc.)
Disease - What do we examine in PATHOLOGY
2., Morphological changes
(→ Pathology)
→ Morphological examinations
Most important Method to recognize/investigate the disease:
1., Autopsy
In the vast majority of the cases complementary investigations are necessary!
What is Post-mortem and ante-mortem investigations
(excision, fine needle aspirate, biopsy samples from living animals)
What is Pathogenesis
(how does the disease proceed)
What is
General pathology:
Study of the reaction of cells or tissues to injury with a focus on the mechanisms of that response.
Basic changes:
– Circulatory disturbances – Regressive changes
– Proliferative changes
– Inflammations
– Tumors
– Developmental anomalies
What is Special pathology/systemic pathology:
Characteristic changes caused by well defined diseases, grouped according to organ systems
What are the Groups according to different characteristics
Localisation, extension
– general, organ and systemic diseases
Aetiology:
– Infectious (morbidity, mortality, lethality)
• Spreading: endemic, epidemic, pandemic
• Agent: bacterial, viral, fungal, parasitic – Noninfectious
Appearance: continous, periodic, paroxysmal
Duration: fulminant, peracute, acute, subacute, chronic

Rupture large intestines - Horse
Staining

Ziehl-Neelsen Staining
Staining

Perls Staining

Immunohistochemistry (IF, IPO), in situ hybridisation
Special staining

MAC-387
Type of lesion

Trichoblastoma, basalioma

Foot and mouth disease in Cattle, Pig and Human
Sanatio
Recovery/Healing
• Recreatio
Mild degree of functional changes, reversible morphological alterations → revivification (recreatio)
• Restitutio
– ad intergrum – cum defectu
Complete recovery following more profound tissue alterations, lost cells are replaced by corresponding tissues → regeneration (regeneratio, restitutio ad integrum/ cum defectu)
• Regeneratio
Complete recovery following more profound tissue alterations, lost cells are replaced by corresponding tissues → regeneration (regeneratio, restitutio ad integrum/ cum defectu)
• Reparatio

• Demarcatio

• Organizatio


Demarcation (abscesses in the lung, horse)
What is this an example of

Callus formation
Permanent morphological or structural changes (restitutio cum defectu) → locus minoris resistentiae
What is clinical death
Clinical death
(no breathing, no heartbeat, but tissues and organs survive for a while → resuscitation, grafts, transplantation, culturing) → pathological agony („intermediate life”) → pathological or absolute death
When is the recognition of death
Recognition of death:
no heartbeat, no responses to sensory or sensitive stimuli, no reflexes (pupils → „brain death”)
→ when post mortem changes start: obvious
What are the postmortem changes?
- Cooling off – algor mortis
- Pale color – pallor mortis
- Desiccation – exsiccatio postmortalis
- Soaking – maceratio postmortalis
- Stiffness – rigor mortis
- Postmortem clot – cruor postmortalis
- PM blood sedimentation – hypostasis postmortalis – Livores mortis
- Discoloration - imbibition
- Selfsoftening – autolysis (selfdigestion –
- autodigestion)
- Postmortem decomposition – putrefaction
- Grave wax - adipocere
Name of lesion?
Due to?
Found where?

Desiccation - exsiccatio postmortalis
Evaporation
Skin
Mucous membranes
Cornea
+ also in alive animals
Characteristics of this postmortem change

- complete dehydration of the tissues
- dry heat and/or air current
- desert, chimney
- Function of the putrefactive bacteria is also hampered
Characteristics of this postmortem change

Soaking, maceratio
- Skin, organs filled with fluid
-
Foetuses
- Aseptic autolysis
- Carcasses staying in the water
-
Also in living animals
- flows on the skin!
Rigor mortis
In which type of muscles?
Nystens Rule
All 3 types of muslcles
Nystens rule - Direction of rigor mortis
- Skeletal muscles → rigor mortis timeline
- 2-4 hours the beginning (head is stiff)
- 5-8 hours becomes general (body)
- 24-48 hours starts to disappear
- 48-60 passes off
Rigor mortis in Heart Muscle
Systole or diastole?
Development?
Duration?
- Standstill in diastole – looks like systole
- Develops fast (30 minutes)
- Lasts for 1 day
Rigor Mortis Smooth muscles
Onset?
Duration?
- Quick process (10-15 minutes)
- Lasts for 1 – 4 hours
- Rigid intestines, arteries, spleen
Onset and duration of RM
Rapid and short
- High environmental and/or inner temperature
- Prolonged muscular activity
- Young and elder animals
- Septicaemia, wasting diseases
Onset and duration of RM
Delayed
- Asphyxial death (notably by carbon monoxide poisoning) = SUFFOCATION
- Severe hemorrhage, cold surroundings
- Fails to develop In case of degenerative muscle changes
What is this
Characteristics

- Postmortem clot - Cruor postmortalis
- Dark red, smooth, fleshy with glistening surface
- Very similar to Trombocytolysis but it isnt attached to the intima
- After death blood clots in 15-30 minutes in large vessels, non in smaller ones

Blood clot in the heart

- PM blood sedimentation, lividity
- postmortem hypostasis
- Effect of gravity on the blood fluid – in 1 hour!
- Also visible inside the organs
- livores mortis → PM spots dark purple

Sulfhemoglobin imbibition

Bile imbibition - From Gall bladder

Hemoglobin imbibition

Self softening - Autolysis
Autolytic ferments of the cell in the cytoplasm
- Autodigestio (self digestion)
- Gastromalatia due to gastric juice
- Oesophagomalatia
What is happening

Postmortem destruction - putrefaction
Decomposition products → Activity of saprogenic bacteria
Suffocation supports the putrefaction → blood remains liquid
Decomposition from Intestine – v. portae – liver
Dissolution into gases, liquids and salts
Ptomaines (neurine, muscarine, putrescin)
Gas production – stomach distension
Under 5 degrees putrefaction stops
Pase of Putrefaction
Rapid VS Slow
- Pace of putrefaction
-
Rapid
- Obese (retaining the body heat)
- Warm environmental temperature
- Hyperemic organs
- Widespread infection
- Injuries (portals of entry)
- Oedematous tissues
- Slow → Lean and Exsanguination (dehydration)
-
Rapid

Putrefaction

EMPHYSEMA POSTMORTALIS HEPATIS
Due to putrefaction

Postmortal Tympany (gass accumulation)

Sulph-hemoglobin imbibition
Reaction of Hb (hemoglobin) plus H2S (hydrogen-sulphid) greyish-green, paling off on air

Sulph-hemoglobin
Reaction of Hb (hemoglobin) plus H2S (hydrogen-sulphid) greyish-green, paling off on air

Sulph-hemoglobin
Reaction of Hb (hemoglobin) plus H2S (hydrogen-sulphid) greyish-green, paling off on air

Sulph-hemoglobin
Reaction of Hb (hemoglobin) plus H2S (hydrogen-sulphid) greyish-green, paling off on air

Pseudomelanosis
- H2S + Fe (from Hb)
- Iron-sulphide

- PM Wax - Adipocere
- Saponification
- In wet, clayey soil
- Fatty acids and Ca++
- Form soaps, impregnate soft organs
- Sweetish odour
What are the causes of cellular damage?
- External causes
- Physical
- Mechanical effects
- High and low temperature
- Electricity
- Radiant energy
- Climate and weather
- Chemical → Intoxications
- Biological → Viruses, bacteria, fungi, protozoa
- Inadequate supplements (malnutrition)
- Physical
- Internal causes

Luxation

bite (vulnus. morsum)

gun-shot (vulnus. sclopetarium)

Bleeding in the brain tissue

Rupture

Tituration

Sequelae of traumatic effects
• Local effects
– Lesions
– Tissue damage
– Port of entry!
Sequelae of traumatic effects
• General effects
– General effect of a local infection
• tetanus, gas-phlegmone
– Loss of blood
• Bleeding out
– Functional disturbances
• fractures, luxations
– Embolism
• fat, bone marrow
– Traumatic shock

Bleeding, Haemothorax

Loss of function
disruption of the Achilles tendon
Lesions in the tissues
Microscopical or Macroscopical
Macroscopic
– Ruptures (ruptura)
– Fractures (fractura)
– Luxation (luxatio)
– Fissure
– Concussion (commotio)
Lesions in the tissue leading to Locus minoris resistenciae
– Ruptures (ruptura)
– Fractures (fractura)
– Luxation (luxatio)
Locus minoris resistenciae
- sick animals
- bad condition
- dietetical problems
Lesions in the tissue
Where can you find Concussions
– Concussion (commotio)
– brain, spinal cord, bone marrow
– bony capsule!!!
– not always seen with naked eyes
Fractures
What do we have?
Special form of fraction
- open (fr. aperta) or covered (fr. optecta)
- special appaerance
– Infraction - bone fracture marked by a small line that shows up in X-ray examination
What can be seen

Dislocation of the broken ends
Which reaction can be seen?
What does it mean?

Vital reaction
Happened in real life
Edges of the wound
– Hemorrhages at the surrounding tissues – After soaking it disappears!
High temp as a cause of disease - Categories
CAUSED BY: Radiant heat, hot liquid, steam, gas, solid substances (live coal, melted metal)
- Categorized by the severity of the lesions
LOCAL EFFECT = COMBUSTIO
- • C. erythematosa
- • C. bullosa
- • C. escharotica
- • Carbonization
(1st) (2nd) (3rd) (4th)
partial depth (epidermis) 1+2
complete depth 3+4
GENERAL = HYPERTHERMIA
Appearance of the Burns

C. erythematosa (1st degree)
Hyperaemic area, vasodilatation, edema
Appearance of the Burns

C. bullosa (2nd degree)
- Vesication,
- Denaturation of proteins,
- Pain
Appearance of the burns

C. escharotica (3rd degree)
- Coagulation necrosis of the tissues
- Hemostasis
- Thrombosis
- Pale
- Insensible
Appearance of the Burn

Carbonization (4th degree)
- Tissues are charred
Inhalational Burns
Inhalation Burns
-
Destruction of airways and lungs
- The mucous membrane of the nasal and oral cavity, upper respiratory system
-
Gasses soluble in water = form acids or base and cause edema
- Chloride, sulphur dioxide, ammonia
- swelling, inflammation

Carbonization (4th degree)
General effects of burns
(exept hyperthermia)
-
Circulatory disturbance, shock… (immediate)
- edema (permeability of the blood vessels)
- pain, hypovolaemia, hyperkalemia, autointoxication
- Necrosis, enzymatic lysis of proteins – increased local osmotic pressure
- Hemoconcentration, desiccation
-
Degeneration of parenchymal organs
- catabolic enzimes continue to work
- liver, kidney, heart, bone marrow! (anaemia)
-
Hyperkalaemia (potassium released from the cells)
- 2nd day: oliguria, anuria (degeneration of tubular cells)
- 3rd day: polyuria (later no water retention ability)
- Toxaemia
General effects of burn
HYPERTHERMIA
Hyperthermia
- Extremely increased internal temperature of the body
-
Hyperthermia = (failure of physical heat regulation)
- High (and humid) environmental temperature
- High own heat production (pyrogens)
- Heat loss is inhibited
- Consequences similar to burn consequences
-
Pathologic findings
- Quickly developing RM, incompletely CLOTTED blood, early PUTREFACTION
- Hemostasis in internal organs, brain edema, meningeal hyperemia, and hemorrhages in the hypothalamus
HYPERTHERMIA
HEAT STROKE
- Heat stroke (> 43°C)
- Lesions
-
Heat spasms
- electrolyte loss (sweating)
-
Heat distress
- most often seen, collapse
- failure of cardiovascular compensatory mechanisms after hypovolemia
-
Heat spasms

Sunstroke - Insolation
- Infrared (ultraviolet?) radiation of sunshine
- Longlasting or strong impact of sunshine
Low temperature as a cause of disease
LOCAL EFFECTS
-
Contraction of vessels, local ischaemia
- Metabolic and waste products (lactic acid, histamin)
- Irregular vasodilatation! - hemostasis
-
Frostbite (congelatio)
- Not only at freezing point - wet, windy surroundings
- Piglet with diarrhea, protruding body parts (ears,tail,testicles)
- Not only at freezing point - wet, windy surroundings
LESION

C. erythematosa (1st)
– bluish-red, swollen
LESION

C. bullosa (2nd)
– vesication, edema

LESION

C. escharotica (3rd)
– necrosis
LESION

C. gangrenosa (4th)
gangrene
Low temperature as a cause of disease
GENERAL effects
(Not hypothermia)
• General effects
– Gangrenous lesions, necrosis
• Toxaemia
Hypothermia at which temp?
Failure of the heat regulation – around 35oC
27-30 oC: vital functions come to standstill
20-25 oC: death
Hypothermia
- Endangered species
- Predisposing factors
- Factor of great metabolic Activity
- pig, rabbit, dog
- diarrhoea, bleeding
- Brown adipose tissue
What are the Defence mechanisms Against falling body temperature
-
Contraction of muscles
- Shivering
- Vasoconstriction in the skin
- Increased metabolism
- Labile glycogen reserves are used up
- Shallow and quick respiration
Name a HYPOTHERMIC wellknown disease
Baby pig disease

• Acute hypoglycemia of the newborn pigs
– Fatal if untreated
– Cold, starvation
• In newborn or young animals
– Heat regulation is not perfect
– Body surface is relatively large
What is autointoxication?
= Autotoxemia
Poisoning the body with endogenous toxins,
Self- poisoning, a pathological condition that occurs as a result of poisoning by substances produced in the body.
(➢Exogenous toxins subject of Toxicology)
Types of autointoxication
NEED TO KNOW
- Stuck of intermediary metabolism
- Retention autointoxication
- Hepatic autointoxication
- Putrid autointoxication
- Abnormal direction of metabolism
- Enterogenic autointoxication
- Resorption autointoxicationn
1. Stuck of intermediary metabolism
DIABETIC AUTOINTOXICATION
DIABETIC TOXINS = KETONE BODIES
Ketone bodies are 3 water-soluble molecules
- Acetoacetate,
- Beta-hydroxybutyrate and their spontaneous breakdown product,
- Acetone
Produced in LIVER from FATTY ACIDS
- Low food intake (fasting), carbohydrate restrictive diets, starvation,
- Prolonged intense exercise
- Untreated (or inadequately treated) TYPE 1 DM
- Stuck of intermediary metabolism
DIABETIC AUTOINTOXICATION
What is KETOSIS and KETOACIDOSIS
- Ketosis is a metabolic state in which most of the body’s energy supply comes from ketone bodies in the blood, in contrast to a state of glycolysis in which blood glucose provides most of the energy.
- KETOACIDOSIS (DKA) is a potentially life-threatening complication in people and animals with DM
➢ It happens predominantly in those with type 1 diabetes.
➢DKA results from a shortage of insulin; in response the body switches to burning fatty acids and producing acidic ketone bodies, causes most of the symptoms and complications.
- Stuck of intermediary metabolism
DIABETIC AUTOINTOXICATION
Symptoms of Diabetic ketoacidosis
- Nausea and vomiting,
- Pronounced thirst,
- Excessive urine production and
- Abdominal pain that may be severe.
➢Dehydration, such as a dry mouth and decreased skin turgor.
➢ Tachycardia (a fast heart rate) and low blood pressure.
➢ Cerebral edema, May cause
- headache,
- Coma,
- loss of the pupillary light reflex, and
- progress to DEATH.
Lesion

Diabetic autointoxication
(pancreas fibrosis, dog)
Lesion

Diabetic autointoxication (pancreas fibrosis, dog)
Lesion

Diabetic autointoxication
(Lipidosis in the liver, dog)
Lesion

Diabetic autointoxication
(Lipidosis in the LIVER, dog)
Lesion

Diabetic autointoxication
(Brain edema, dog)
LESION

Diabetic autointoxication
(Brain Edema, dog)
What is Retention autointoxication(2)
3 types
Develops in excretory organs, accompanied by a delay in the removal of metabolic products from the body.
➢Kidney failure = uremia
➢Uricosis (gout)
➢Icterus (hepatopathy)
Retention autointoxication(2)
Uremic autointoxication
Solutes/Uremic toxins
Classification of uremic toxins
Characterized by the retention of various solutes that would normally be excreted by the kidneys.
- Creatine,
- Creatinine,
- Urea
- Uric acid.
➢Low-molecular-weight, water-soluble uremic toxins
➢Protein-bound solutes
➢Middle-molecular-weight molecules
Retention autointoxication(2)
Uremic autointoxication
What are the consequences of UREMIA?
- Seizure, coma, cardiac arrest, and death.
- Spontaneous bleeding (vascular damage)
- Electrolyte
- Kidney failure
- ➢MULTIORGAN FAILURE
Lesion

Uremia (kidney-fibrosis, dog)
Lesion

Uremia (kidney-fibrosis, dog)
Lesion

Uremia (kidney-fibrosis, dog)
Lesion

Uremia (necrotic glottisis, cat)
Lesion

Uremia (uremic gastritis, dog)
Lesion

Uremia
(uremic encephalopathy, dog)
Lesion

Uricosis (Bird)
Lesion

Uricosis
Granuloma (TOPHUS)
3. Hepatic autointoxication
Retention of bilirubin, decreased detoxification of the gastrointestinal toxins
(enterogenic autointoxication).
➢Damage of the liver parenchyma can occur:
▪ Hepatitis (inflammation)
▪ Hepatosis (degeneration)
▪ Tumor (primary, secondary)
▪ Fibrosis (necrosis, scar-formation)
▪ Cirrhosis
3 PHASES
- Hepatic autointoxication
PHASE I - Detoxification pathway
Consists of
- Oxidation,
- Reduction
- Hydrolysis
Catalysed by enzymes referred to as the (=PROTECTION)
- Cytochrome P450 enzyme group or
- Mixed Function Oxidase enzymes (MFO).
- Hepatic autointoxication
What is Impaired hepatic detoxification?
Refers to decreased phase I and/or phase II enzyme activity
= The levels of hepatic detoxification enzymes decreased.
- Hepatic autointoxication
Phase II - detoxification pathway
This is called the conjugation pathway, whereby the liver cells add another substance (eg. cysteine, glycine or a sulphur molecule) to a toxic chemical or drug, to render it less harmful.
This makes the toxin or drug water-soluble, so it can then be excreted from the body via watery fluids such as bile or urine.
- Hepatic autointoxication
What is the toxic effect of BILIRUBIN
➢Bilirubin is toxic in most biological systems tested.
➢Several mechanisms have been suggested for this toxic effect,
- Including inhibition of enzyme systems and
- Inhibition of cell regulatory reactions (protein/peptide phosphorylation).
- Hepatic autointoxication
What is the toxic effect of BILIRUBIN in the BRAIN
When the serum level of unconjugated bilirubin exceeds the albumin binding capacity, bilirubin diffuses into the central nervous system and may result in permanent neurological damage or death
(bilirubin encephalopathy with kernicterus).
- Hepatic autointoxication
What is the toxic effect of BILIRUBIN in the BRAIN
What does BIND refer to?
Bilirubin-induced neurologic dysfunction (BIND) refers to the clinical signs associated with bilirubin toxicity (ie, hypotonia followed by hypertonia and/or opisthotonus or retrocollis) and is typically divided into acute and chronic phases.
Lesion

- Hepatic autointoxication
Toxic effect of Bilitubin to the brain
Lesion
Which toxic component?

Billirubin
- Hepatic autointoxication
➢Impaired hepatic detoxification can result from which intrahepatic causes:
- exposure to
- Food additives,
- Solvents,
- Toxins,
- Viral infections,
- Gilbert’s syndrome,
- Hyperthyroidism,
- Restricted bile flow (Cholestasis)
- Hepatic autointoxication COMPLICATIONS
➢The presence of chronic fatigue is a frequent symptom.
➢Depression, general malaise
➢Headaches, digestive disturbances, allergies and chemical sensitivities, constipation
➢Mental confusion, mental illness, tingling in extremities, abnormal nerve reflexes, and other signs of impaired nervous system function
Lesion

Liver cirrhosis (dog)
Lesion

ICHTERUS
Ichterus coagulopathy
- Histolysis/heterolysis by gangrene = putrid autointoxication
What is gangrene?
Gangrene (or gangrenous necrosis) is a type of necrosis (ichorous inflammation).
- Histolysis/heterolysis by gangrene = putrid autointoxication
Types of gangrene
The types of gangrene differ in symptoms, and include:
- dry gangrene,
- wet gangrene,
- gas gangrene,
- internal gangrene.
Lesion

Gangrene
- Histolysis/heterolysis by gangrene = putrid autointoxication
Dry Gangrene
Dry gangrene is a form of coagulative necrosis that develops in ischemic tissue, where the blood supply is inadequate to keep tissue viable.
➢ The limited oxygen in the ischemic tissue limits putrefaction and bacteria fail to survive.
➢ The affected part is dry, shrunken and dark reddish-black.
➢ The line of separation usually leads to complete separation, with eventual falling off of the gangrenous tissue if it is not removed surgically, a process called autoamputation.
Lesion

Dry gangrene
- Histolysis/heterolysis by gangrene = putrid autointoxication
Wet Gangrene
Wet, or infected, gangrene is characterized by thriving bacteria and has a poor prognosis (compared to dry gangrene) due to sepsis resulting from the free communication between infected fluid and circulatory fluid.
Lesion

Wet Gangrene
Which bacterias can cause wet gangrene?

In wet gangrene, the tissue is infected by saprogenic microorganisms
(Clostridium perfringens or Bacillus fusiformis, for example),
which cause tissue to swell and emit a fetid smell.
What happen due to wet gangrene?

➢ The toxic products formed by bacteria are absorbed, causing the systemic manifestation of sepsis and finally death.
➢ Necrotoxins!!!
➢ The affected part is edematous, soft, putrid, rotten and dark.
Lesion

Pneumonia ichorosa (bo)
Lesion

Pneumonia ichorosa (bo)
Wet gangrene
5) Abnormal direction of metabolism
Name a special type that accumulate with high metabolism = abnormal metabolism
The porphyrias are a group of rare diseases, in which chemical substances called porphyrins accumulate with high metabolism. (picture: swine) abnormal metabolism
Lesion

Porphyrias - porphyrins accumulate with high metabolism. (picture: swine) abnormal metabolism
6. Enterogenic autointoxication, enterotoxaemia
How?
Why?
By what?
– Absorbed decomposition products from gastro- intestinal system
Grass fever: methylindol, grass- sickness: Cl. botulinum,
Enterotoxaemia: Cl. perfringens
Lesion

Enterogenic autointoxication, enterotoxaemia
Lesion

Enterogenic autointoxication, enterotoxaemia
6. Intestinal autointoxication/toxic colon
Nothing highlighted
➢The colon’s main responsibility is the elimination of toxins with the feces.
➢Toxins in the feces (intestinal toxins):
- indol,
- skatol,
- phenol,
- methylmercaptan,
- urobilin,
- histidine,
- ammonia,
- putrescine,
- neurin,
- cadaverin,
- butyric acid,
- cholin,
- methylguandinine.
➢Constipation intestinal autointoxication/toxic colon.
Lesion

Intestinal autointoxication/Toxic colon
Lesion

Intestinal autointoxication/Toxic colon
7) Resorption autointoxication
7. Absorbed metabolites from special cases:
= Ruptured, perforated, arrodated stomach, intestine or urinary bladder.
Lesion

Ruptured, perforated, arrodated stomach, intestine or urinary bladder.
Lesion

Ruptured, perforated, arrodated stomach, intestine or urinary bladder.
Lesion

Ruptured, perforated, arrodated stomach, intestine or urinary bladder.
Lesion

Ruptured, perforated, arrodated stomach, intestine or urinary bladder.
Lesion

Ruptured, perforated, arrodated stomach, intestine or urinary bladder.
Morphological complications of the autointoxication
Degeneration and enlarged of parenchymal organs (liver, kidney, heart, CNS)
Hydropic or vacuolar degeneration: histopathologically large cytoplasm: swelling, enlarged mitochondria.
Lesion

Toxic hepatopathy/vacuolar hepatopathy/non-specific hepatitis
LEsion

➢Toxic myodegeneration/myocardosis
LEsion

➢Toxic nephropathy/acut tubular degeneration-necrosis
Lesion

➢Toxic encephalopathy
Lesion

➢DIC (Disseminated intravascular coagulopathy/microthrombosis)
- Internal conditions of development of diseases
(predispositio) + resistance (resistentia)➔development of a disease.
Predisposition and resistance constitution) and acquired characteristics (condition).
- Internal conditions of development of diseases
What is Genetic predisposition
➢An individual may not be born with a disease but may be at high risk of acquiring it. This is called genetic predisposition or susceptibility.
- Internal conditions of development of diseases
What is Constitution
= Somatotype
Categorize the human physique according to the relative contribution of 3 fundamental elements, somatotypes
- Internal conditions of development of diseases
What are the different somatypes?
1) Normosom type (typus muscularis, typus athleticus) muscular-athletic physique [mesomorphic]
2) Leptosom type (typus respiratorius) prone to emaciation [ectomorphic]
3) Pycnic type (typus digestivus) prone to obesity [endomorphic]
- Internal conditions of development of diseases
What is diathesis?
„Defective” constitution➔predisposition for certain diseases (diathesis)
- Internal conditions of development of diseases
Diseases can be?
Congenital or Hereditiary
- Internal conditions of development of diseases
What is HEREDITIARY diseases?
- The defective constitution and the connected functional changes are inherited
- Can be dominant, recessive or intermedier
- Can be recognized at parturition or can manifest later
- If it is life-threatening: lethal factor
- Predisposition for certain diseases: diathesis
- Internal conditions of development of diseases
What are CONGENITAL diseases?
Effects that harm the fetus
In avian species: ovogen infection (Salmonella gallinarum, goose parvovirus, etc.)
Important role in diatheses:
- Species (susceptibility, eg. classical swine fever)
- Breed, race (breeding those with natural resistence to a disease [eg. avian leukosis])
- Gender
- – ♀ cystitis
- – ♂ urolithiasis
- Age (young animal: omphalitis; old: digestive diseases)
- Individual (not all individuals are affected by the same disease/agent)
- Organ
- – bone: fracture
- – liver: rupture
- – muscle: laceration
The congenital and acquired resistence is:?
IMMUNITY
- Infectious agents as causes of disease
What is infection?
Infection:
spreads from animal to animal, through direct or indirect route (fomites, vectors, iatrogen etc.)
- Infectious agents as causes of disease
What is Invasiveness:
Invasiveness:
The pathogen is able to spread inside the organism (not all pathogens have this feature: e.g. Cl. tetani)
- Infectious agents as causes of disease
Infectious pathogens:
Parasites, fungi, bacteria, viruses, prions
- Infectious agents as causes of disease
Parasites
-
Ectoparasites (dont enter organism)
- stress, weakening factor (blood loss), „locus minoris resistentiae”
-
Endoparasites (infectious):
-
Multicellular
- Malnutrition, blood loss, weakening, atrophy, mucosal membrane lesions, autointoxication
-
Unicellular
- Intracellular Babesia causing cell damage
- Extracellular toxoplasma causes formation of toxic products
-
Multicellular
- Infectious agents as causes of disease
Fungi
Mycotoxicosis(noinfection!)
Dermatomycosis (superficial invasion: skin, claw, hoof, mucosal membrane) → loss of hair, irritation, stress (itching), „locus minoris resistentiae” (changes in structure)
Visceral mycosis (local inflammatory processes, granuloma formation, thallus-formation, thrombotisation, thromboembolism, metastasis)
Lesion

Fungi
Lesion

Fungal granuloma formation in the lung
Lesion

Fungal thalus formation in the air sac
- Infectious agents as causes of disease
Bacteria
- Obligatory and facultative pathogens, intracellular and extracellular
- Bacterial Infections
- Local
- The pathogen enters the body, but does not certainly spread, often in wounds, abscesses
- Systemic
- Pathogen enters the body, and spreads → sepsis, bacteraemia
- Local
- Infectious agents as causes of disease
Viruses
- Obligatory intracellular pathogens, modify the physiological metabolic processes of the infected cell
- Local infection
- Systemic infection (affects only a certain tissue type or organ system: e.g. rabies),
- Generalised infection (viraemia)
- Infectious agents as causes of disease
Prions
- Modulator-proteins, modify the metabolic processes of the cell
- Damage: neuron degeneration, encephalosis
Lesion
Cause of lesion

Bovine spongiform encephalopathy (BSE), „mad cow syndrom
PRIONS
Immune response
Types
- Innate
- – Nonspecific for antigenes
- – Immediate reaction
- – No memory
Adaptive
– Specific for antigenes
– Slower reactions at first (days to weeks)
– Memory – fast reaction! (see vaccination)
Immune response
Innate immune response
Anatomic barriers
- (skin, mucous membranes) and
- Physiologic properties (stomach pH, body temperature) + Phagocytosis, complement system
Adaptive immunity
Responses
Adaptive immunity • 2responses:
– Cellular immunity (T lymphocytes against intracellular pathogens)
– Humoral immunity (B lymphocytes against extracellular pathogens and toxins)
T-Cell = Specific antigen binding molecule is T cell receptor (TCR) (only recognizes antigen if bound to MHC molecule!)
B-Cell = Membrane bound immunoglobulin (can recognize single antigen as well)
Phagocytic cells include
- macrophages,
- dendritic cells,
- granulocytes (eosinophil, basophil,neutrophil),
- Mast cells
Types of cells

Macrophages
Types of cells

Dendritic cells
immature to the left, and mature to the right
Type of cells

NEUTROPHIL Granulocyte
Type of cell

EOSINOPHIL Granulocyte
Type of cell

BASOPHIL Granulocyte
Type of cell

MAST cell
Type of cell

NK-cells (phagocyting a tumor cell)
What is Mononuclear phagocytic system (MPS)
Role in immunity, inflammatory processes,
• Monocyte is the name in circulation
In Tissues =
- Histiocytes
– Resident macrophages
- Kupffer-cells in liver,
- Alveolar macrophages in lungs
Major role in phagocyting endogenous and exogenous pathogens
What is CYTOKINES
- Messenger molecules of the immune system
- Low-molecular-weight
- Soluble glycoprotein proteins
- Largely, they are produced locally, and act LOCALLY
- (but also SYSTEMIC effects: fever, lethargy, inappetence)
- They direct the immune response
- Oversecretion can be fatal: cytokine storm
What is this
Mature Lymphocyte
What is this

Reactive lymphocytes
What are the 3 major groups of the immune system disorders?
- – Hypersensitivity reactions
- – Autoimmune diseases
- – Immunodeficiencies
What is hypersensitvity? (immune system)
1) Hypersensitivity
• Altered intensity of immune response, leading to pathologic lesions
- 4 GROUPS
What is Type I hypersensitivity
– Type I (immediate)
- allergies,
- anaphylaxy
What is type II Hypersensitivity?
Type II
- (CYTOTOXIC)
- haemolytic anaemias
What is type III Hypersensitivity?
– Type III
- IMMUNE COMPLEX
- Arthus reaction,
- Systemic lupus erythematosus (SLE),
- Rheumatoid arthritis
What is type IV Hypersensitivity
– Type IV
- (DELAYED)
- tuberculin test,
- contact dermatitis
Lesion

TYPE I Hypersensitivity
IMMEDIATE
ATOPIC DERMATITIS
LEsion

TYPE IV HYPERSENSITIVITY
DELAYED
CONTACT DERMATITIS
Lesion

TYPE III Hypersensitivity
IMMUNE COMPLEX
SLE = Discoid lupus erythematosus (s= systemic)
2) Autoimmune diseases
- Specific immune response to self-antigens
- Multifactorial etiology
- Autoantibodies
- 2 main mechanisms:
- normal immune response to abnormal antigen
- abnormal immune response to normal antigen
- Result: tissue damage and inflammation
2) Autoimmune diseases
Example of a
- • Autoreactive antibodies disease
- • Lymphoplasmocytic inflammation and fibrosis
- • Chronic inflammation
- • Organ specific autoimmune diseases
- • Autoreactive antibodies disease = SLE (ANA-test)
- • Lymphoplasmocytic inflammation and fibrosis = keratoconjunctivitis sicca, KCS
- • Chronic inflammation = Rheumatoid arthritis
- • Organ specific autoimmune diseases = pemphigus, uveodermatologic syndrome, autoimmune haemolytic anaemia (AIHA)
Lesion

PEMPINGUS
Autoimmune disease
Lesion

Uveodermatologic syndrome
Autoimmune disease
LEsion

Autoimmune disease
Rheumatoid arthritis
3) Immunodeficiency syndromes
- Failure Of The Immune System Response To pathogens
- Can be primary (congenital or hereditary) or secondary (acquired)
- Not always causing health issues (e.g. Pelger- Huët anomaly)
-
SCID (severe combined immunodeficiency)
- failure to produce specific immunity
- Can affect only T cells, T- and B cells
- Mostly by fungi and viruses
- Feline immunodeficiency virus (FIV), malnutrition, stress, tumors, aging, chronic diseases cause secondary immunodeficienies
Lesion

Normal and SCID Thymus (dog)
Lesion

Gingivostomatitis, cat
FIV?
Lesion

Lymphoid depletion in Peyer’s patch, enteritis, cat small intestine
Electricity as cause of disease
Electric shock – death: electrocution
The higher the voltage the less the resistance!!!
Alternity current is more dangerous than direct current!
Medium amperage cause disturbances
– Brain – loss of consciousness,
– Heart failure – cardiac arrest
Lesion

Common Kestrel (Falco tinnunculus)
Lesion

Lightning
Lesion

Lightning
Radiant energy
• Electromagnetic rays
– Ultra-short waves (microwaves - warming)
– Infrared waves (warm surface radiations)
– Visible rays (physiological effect)
– Ultraviolet rays (biological - path. effect!)
What is Radiant energy
• Ionizing rays
- positive or negative charges
– Effect: dose, ionization, penetrability
– Cosmic rays
– Particular radiations (alpha, beta, proton, neutron, deuteron rays)
– Electromagnetic rays (X- and gamma rays)
Irradiation sickness
-
Phase I (initial phase – after 1-2 hours)
- dizziness, vomiting, exhaution, anorexia, nervousness – alopecia
- Phase II (latent phase) – 1-2 days without signs
-
Phase III (sickness – after a week)
- Bone marrow lesions: hemopoietic insufficiency
- No phagocytosis, no antibody production
-
Phase IV (break down - 4-5 months after)
- diarrhea,
- anemia,
- kidney & liver failures etc.
- malignant tumors
Lesions
Radiations
Lymphocytes
– lymphopenia, smaller lymphonodes
Bone marrow – hypoplasia
Testicles, ovaries – atrophia, fibrosis
Lens
– opacity
Skin
– ulcers,tumors
Cartilage
– retarded growth, malformation of the legs
Fetus
– developmental anomalies
What are the External causes of diseases
- Physical effects
- Chemical effects
- • toxicosis
- Biological effects
- Infectious agents
- Virus, bacteria, fungi, prions, protozoa
- Inadequate supply Oxygen, water, nutrient
What are the Disturbances in oxygen supply
- Suffocation = (asphyxia) – lack of air
- Hypoxaemia = insufficient saturation of the blood
- Hypoxia = insufficient saturation of the tissues
- Hypercapnia = increased CO2 level in the tissues

Pathology of the suffocation
- Dark, unclotted blood
- • Petechial hemorrhages
- serosal membranes, larynx, trachea, heart
- Acute lung hyperemia and edema
- Acute dilation of the heart
- Acute emphysema
- Differentiate from septicaemia!
Lesions due to

Pathology of suffocation
• Petechial hemorrhages
serosal membranes, larynx, trachea, heart
Acute dilation of the heart
Acute emphysema
Differentiate from septicaemia!
Lesions due to

Pathology of suffocation
Dark, unclotted blood
• Petechial hemorrhages
serosal membranes,
Acute lung hyperemia and edema
Acute emphysema
Differentiate from septicaemia!
Disturbances in water supply
-
Exsiccosis, dehydration
- Lack of water intake
- Fluid loss never stops – eg. evaporation
- Relatively high mineral content, pH shift
- Increased fluid loss
- Vomiting, diarrhea, perspiration
- Lack of water intake
-
Hyperhydratio (water toxicosis)
- Loss of minerals and electrolites
- Pathological changes seen in skin (skin fold test), sunken eyes
Lesion

Dehydration
Lack of water intake
Increased fluid loss
- Diarrhea
Lesion

Dehydration
Disturbances in nutrient supply
Total starvation
Total starvation (Inanitio completa)
– No food intake (energy, protein)
– 40-50 % of the body: death (Cachexia)
Disturbances in nutrient supply
Partial starvation,
Malnutrition (Inanitio incompleta)
– Food supply is not adequate
– Deficiency diseases
Disturbances in nutrient supply
Obesity,
Overfeeding (Obesitas)
– Surplus of feed or feed components
– Continuous or occasional (dilation and rupture of the stomach)
– Other causes (lack of movement, hormonal disorder)
Incomplete starvation, malnutrition
• Causes
– Feed
• Quantity or quality (ingredients)
– Normal feed, but
• Inadequate food uptake
• Pathological lesions of the digestive tract
• Digestion - Maldigestion
• Absorption - Malabsorption
• Deficiencies
– Increased need
• Consequence: deficiency diseases
What is the Consequence of autointoxication (Nutrient)
– increased fat and protein catabolism → ketonaemia
Lesion

Cachexia
Lesion

Obesitas
Lesion

Cachexia
LEsion

Cachexia
Lesion
Cachexia

Lesion

Oedema cachecticum
Lesion

Cachexia
Infectious agent
Spreading?
Agents?
- Spreading among animals
- Within the animal: infectious agents, tumors as wel
- Prion (TSE, BSE)
- Viruses (DNS, RNS, enveloped, non enveloped)
- Bacteria (Gr+, Gr-)
- Chlamydia, Mycoplasma
- Fungi
- Protozoa
- Helminths
- Ectoparasites
Skin infections
– Transcutan infection

- Intakt skin: dermatophytosis, Malassezia
- Through lesions: papilloma, rabies (!), tetanus
- Arbo = arthropode born: babesiosis, Lyme-disease, infec. anaemia, WNV, African swine fever
Spread of pathological procecces in GI tract
Gastrointestinal tract
- Gastric **acidity, pH 1-2
- Viscous**mucus
- Digestive enzymes, detergents in the bile
- Defensins
- Normal intestinal flora
- Secreted IgA antibodies (MALT)
Lesion

RESPIRATORY
Type II pneumocytes (surfactant, regeneration,
phagocytosis, immunregulation)
What is an AEROSOL
Aerogen (airborne) infection
Oronasal, conjunctival infection affects
bird flu, fowl cholera
urogenital infection:
– venereal infection, semen, or erosions on the mucus membranes (Brucellosis, AIDS, dourine)
– urinary or genital infections: FLUTD, cystitis; pyometra
Infections via the umbilical cord,
omphalogen:
E. coli,
Salmonella
Vertical infections
transplacental or intrauterine infection (BVD, PRRSV)
ovogen infection: Salmonella
Incetions caused by the veterinarian
Iatrogenic infection: PCV2, EBL
What are the Factors affecting spread of pathogens and the disease:
Infectivity (ability of pathogen to establish infection)
Pathogenicity (capacity to cause disease)
Virulence (ability to decrease the fitness of the host)
Host specificity (PRRSV, Aujeszky disease)
Invasivity (tetanus, anthrax, FIPV!!)
Immunological function of the host
Contagiousness (ability to spread) rabies, FMD
– Temperature (CHV, rhinoviruses)
– Humidity, other environmental factors
Spread of pathological processes in the organism
- Pathogen in the organism
- At the site of entry (portal of entry)
- Primary process
- Metastasis
What is METASTASIS
= SPREADING of PAHOGEN
metastasis is the name of – the process
– the secondary lesion
• metastasis: a lesion identical to the original (primary) one
Can be an active process: migrating parasites!!!
Types of metastasis
- Local
- Regional
- Distant
Local metastasis
to the surrounding areas
direct spread
Regional Metastasis
to regional lymph nodes
via the lymphatic circulation
Distant Metastasis
= To Distant organs
- lymphogen = retrograde lymphogen metastasis
- haematogen = phagocytotic embolic
- Intracanalicular = ascending descending
Spread of pathological processes in the organism
Mostly spread through the
Veins
V. portae V. hepatica
V. pulmonalis V. umbilicalis
What is the outcome of Spreading of pathological processes in the organism?
GENERALIZATION
DIFFERENT FORMS of spreading of pathological process in the organism
• Bacteriaemia
– bacteria in low number
– only temporarily
• Septicaemia - sepsis
– lots of bacteria
– for prolonged time
• Pyaemia
– pus gets in the circulation
– the content of an abscess gets in the bloodstream
• Viraemia
– free or cell-associated
What could lead to Septicaemia
- Bacteria in the organs as well
- Settlement in the organs (bacterial-emboli, phagocytotic metastasis)
- Septicemia by Mycoplasmas – Mycoplasmaemia
- Pyogen bacteria (sepsis)
- Rottening bacteria (sapraemia)
What does SIRS stand for
Systemic inflammatory response syndrome
Result of SIRS
- High TNFα and LPS (Gr- bact) levels: DIC
- Liver damage: decreasing glyconeogenesis
- High NO levels: vasodilatation – decrease blood pressure
- SEPTIC SHOCK
Pathology of SEPTICEMIA
- Incomplete rigor mortis
-
Dark red blood, incomplete post mortem coagulation
- – fast putrefaction, and haemoglobin imbibition
- Spleen enlargement (septic splenitis)
- Generalized lymphadenomegaly
- Acute catarrhal inflammation in the GI tract
-
Haemorrhages everywhere
- – Mucous membranes, under the serous membranes, in the cortex of the kidneys
- Cloudy swelling in the parenchymatous organs (liver, kidneys, heart and skeletal muscle)
Lesion

Septicemia
Enlarged Spleen
Lesion

Septicemia
Generalized lymphadenomegaly
Lesion

Septicaemia
Cloudy swelling in the parenchymatous organs (liver, kidneys, heart and skeletal muscle)
Mechanisms of cell injury
GENERAL CONSIDERATIONS
- Cellular response depends on the – type, duration, severity of the harm
- Consequences depend on the – type, condition, adaptability of the cell
- Cellular injury results from functional, and biochemical abnormalities in one or more
essential cell component:
Mechanisms of cell injury
ATP synthesis
Oxidative phosphorylation, anaerobic glycolysis (liver cell vs. neuron)
- If ATP decreases (hypoxia, or toxin)
- Rise in IC Ca++ : enzyme activation
-
Mitochondrial damage (increased Ca++ levels, phospholipases, ROS)
- – Cytochrome c leakage - APOPTOSIS
- ROS levels rising (free radicals)
- Membrane permeability defects
What is REPERFUSION INJURY
• In certain cases cells may undergo more severe damage after the blood flow is restored after ischemia
What is the different nuclear changes?
Nuclear changes
- Nuclear membrane hyperchromatosis
- Karyopycnosis
- Karyorhexis
- Karyolysis
Lesion
Karyorhexis
Lesion

Damage of the cell surface organelles
Regressive changes in the organs

ATROPHY
Factors of the circulatory system
Circulatory system
• Blood
• Heart
• Network of vessels
– Blood distribution – arteries – Blood collection – veins
• Microcirculation
– between blood and extravascular tissue – exchange of nutrient and waste products
• Lymphatics
– draining fluid into the blood vascular system
Normal circulation depends on
- Heart (mechanical energy)
- Valves (cardiac, aortic, venous)
- Elastic walls of blood vessels
- Pressure differentials
- Volume of the blood
- Distribution of the blood
• Hydrodynamic factors
Regulation of blood circulation depends on
- • Hydrodynamic factors
- • Neurohormonal regulation
-
• Vasomotion control
- maintaining harmonized calibre change in the vessels
- • Terminal circulatory bed
What is importaint about the Terminal circulatory bed
- Section between the arterioles and venules
- Major place of circulatory disturbances

What is the Role of the endothelium
• Function:
- To maintain blood in a fluid state
- Anti-thrombotic and pro-fibrinolytic
- Upon injury opposite effect
• Critical participant:
- Fluid distribution, inflammation, immunity
- Angiogenesis, hemostasis
What are the circulatory disturbances?

=Alterations in blood flow and perfusion
• Local:
-
Hyperemia
- In the artery
- Active hyperemia
- A slowdown of the arterial flow
-
• In the vein:
- Local venous congestion
- Systemic venous congestion
- In the artery
- Ischaemia
• General:
– collapse
– shock
What is Prehemostasis
• Plasma leakage
• Extravasation
– RBCs
– WBCs
• In case of inflammation
• Strong stimuli
– mechanical, thermal, chemical or toxic
Pathology of circulatory disturbances
• On the body surfaces of alive animals
• Increased blood flow
– Bright red, slightly swollen, warm area
• Decreased blood flow
– Bluish red, swollen, colder
• Distended blood vessels appear
– Vascular injection
Lesion

Circulatory disturbances
HYPERAEMIA?
What is this a picture of

Hyperaemia due to decreased blood flow
what is this a picture of

Local Congestion
Circularoty disturbance
Local Congestion, what does it mean
Local congestion
• Passive process
• Blood accumulates and slows down in the venous circulation
– prehemostasis, hemostasis
• Vein is obstructed or compressed
– Torsion of the intestine
– Strangulation of the spleen
– Thrombosis
Lesion

Circulatory disturbance
Local congestion
Pathology of congestion
• ORGANS
– Dark red, bluish red, cyanotic
– Swollen
– Large amount of blood on the cut surface
• Mucosal membranes (SKIN)
– Dark red, bluish-red, swollen
– Edemic submucosa
– Wrinkled
– Serous fluid in the lumen of the organ
LEsion

Congestion
Lesion

Congestion due to torsion of one uterine horn
Lesion

Congestion
What is Infarceratio
= Venous Infarct
- • Infarceratio haemorrhagica
- • Long lasting or final obstruction of a vein
– No nutrient or oxygen supply
– Plasma and RBCs in the tissues
– Necrosis of large area
(similar to hemorrhagic infarct)
Lesion

Slow occlusion
What is slow occlusion
Slow occlusion
- Collaterals enlarge
- Remodel
- Drainage is maintained
• Liver cirrhosis
Lesion

Systemic Venous Congestion
What is Systemic venous congestion
• Not only the terminal circulatory bed is affected
• Causes
– Acute or chronic heart failure
– Paralysis of the vasomotor center
– Shock
• Appearance
– In all the organs
Pathology of Systemic Venous Congestion
• Liver
– First centrilobular, than general
– Chronic case: nutmeg liver
- *• Spleen**
- *– Hyperemic septic splenitis !**
- Kidneys (medulla only)
- Lung (plus edema)
• Intestines
– Dark from the serous membranes
Lesion

Systemic venous congestion
Lesion

Chronic case of systemic venous congestion of the liver
NUTMEG
Lesion

Congestive induration - Liver
What is Congestive INDURATION
Congestive induration
• Chronic congestion
• Parenchyma is destroyed
- Replaced by collagen fibrous connective tissue
- Pathology:
– Firm, moist content is less on the cut surface
What is ISCHAEMIA
Ischaemia
• Local inadequate blood supply
– General: anemia, hypovolemia
• Physiological
– Digestion, uneven distribution of blood
• Pathological
- – Compression
- – Obturation
- – Vasoneurotic disturbance
• Consequences
What are the different types of ISCHAEMIA
Ischaemia
- Ischaemia compressiva– Tympany (horse, cow, rabbit, etc.) – Tumors
- Ischaemia obturativa – Thrombus, embolus
- Vasoneurotic ischaemia– Angiospasm (CNS, cold, chemical subs.)
- Collateral ischaemia
Name the cases

A= Thrombosis
B= Compression
C= Embolism
D= Vasculitis
Name the cases

E= Spasm
F= Steal
G= Atheroma
H= Hyperviscosity
What are the Consequences of the ischaemia
• Depends on
– degree and type of narrowing, time, type of tissue, collaterals (lung, liver)
• Collapsus / shock
• Necrosis - Infarct:
– Infarctus haemorrhagicus
– Infarctus ischaemicus
What is an infarct
Infarct
Definition
-
Necrosis of circumscribed area of a tissue due to acute ischemia
- The vessels are obturated
The circulation of tissue
- End arteries
- No anastomotic channel
- Anastomotic arteries
- Kidneys

What is an Ischemic infarct
- • End arteries
- Area becomes bloodless, necrotic
- Appearence:
- Pale grey, dry
-
The margin of the infarct is reddish
- The collateral vessels are full with RBCs
- Location
- Kidneys,
- heart,
- spleen,
- brain
- Infarct pathology
- Formation of the infarct
- Pale, swollen, no sharp edges
- Histochemical methods are needed
- Fresh infarct
- Cone shaped, pale, enlarged, sharp
- edged, cut surface is still moist (!)
- Evolved infarct
- Cut surface dry, homogenous, crumbled
- Dark red, hyperaemic rim
- Older or chronic infarct: Surrounded by demarcation zone, scar

Older/chronic infact with demarcation

Ischemic infarcts, kidney, swine, cross section

Infarct

Infarct

Colonic mucosal necrosis, horse

Ischemic infarct, heart
What is Hemorrhagic infarct
• Double circulation
– In the necrotic area the vessels are filled with RBCs
• Red (darker), dry
– Location
• Lungs, kidney, spleen, liver


Haemorrhagic infarct, testicle, dog

Haemorrhagic infarcts, spleen, dog

Haemorrhagic infarcts, kidney

Haemorrhagic infarcts,
Consequences of an infarct
• Nature of vascular supply
– Double (lungs, liver) or end-arterial (kidney, spleen)
• Rate of occlusion development
– If it is slow, collateral blood supply maydevelop
• Vulnerability to hypoxia
– Neurons (3–4 min)
– Myocardial cells (20–30 min) – Fibroblasts (hours)
• Oxigen content of the blood
• Death
– Insufficient – Heart
– Lung
• Survival
– Reactive inflammation
– Repair
– Organisatio – connective tissue

Consequenses of an infarct
Infarct =
arterial occlusion
Infarceration =
venal occlusion
What is Haemostasis
arrest of bleeding
• finely regulated physiologic response
Steps of Haemostasis
- Steps of hemostasis
-
Primary
* Transient vasoconstriction, platelet aggregation to form a platelet plug
-
Primary
-
Secondary
* Coagulation to form a meshwork of fibrin
* intrinsic (XII activation) and extrinsic (TF – VII activation)
* common pathway activation of X, FIBRIN formation
-
Secondary
-
3. Thrombus dissolution
- thrombus retraction by plasmin, fibrinolysis
- 4. Tissue repair at the damaged site
What are the Disturbances of microcirculation
- Prehemostasis –blood flow slows down
-
Hemostasis – stop of the blood flow
- In the terminal bed
- Leakage
- Reversible
- Posthemostasis – start of the blood flow
- Peristasis – slow bloodflow

Stasis
Definision of SHOCK
Cardiovascular collapse
– A syndrome resulting from a disproportion between blood volume and volume of the circulatory system (1:6)
– Profound circulatory failure resulting in life-threatening hypoperfusion of vital organs
- Types of Shock
- Cardiogenic: Acute or chronic heart failure
-
Hypovolemic
- Blood loss and Reduced circulating blood volume
- Fluid loss is secondary from vomiting, diarrhea, burn
-
Blood maldistribution
- Neurogenic → vasodilatation (paralysis of the vasomotor center)
- Anaphylactic - type I hypersensitivity reaction
- Septic (endotoxin)
What is the cause of septic shock
Caused by
Gr- lipopolisacharid (LPS);
(Gr+, fungi as well without LPS) and
Cytokins, vasoactive mediators
What are the phases of Shock
1. non-progressive
– compensation
– baroreceptors
2. progressive
– inadequate compensation
3. irreversible
– severe metabolic acidosis
– Insufficient blood supply of the vital organs (brain, kidneys), DIC
Pathology of Shock
- Hemorrhages
- Congestion in the abdominal organs (intestines)
- Transsudate in the abdominal cavity, liver and lung edema
- Acute dilatation of the heart
- Ischemia in the kidney (oliguria)
- Hyalin-thrombus in the small blood vessels
- Subacute case
– degeneration in liver, kidney, heart muscle

Shock
Haemorrhages

Liver edema
Cause of shock

Ischaemia in the kidney
Shock

Shock gut piglett
What is an Hemorrhage
– extravasation in a live animal
What is • Thrombosis
(Embolism)
– inappropriate formation of intravascular thrombus
• Hemorrhage + thrombosis =
(DIC)
Expressions
Epistaxis?
nosebleed
Expressions
Hematemesis
– bloody vomit
Expressions
Hemoptoe
expectoration
Expressions
Haemarthros
blood in the joints
Expressions
Hematuria
blood in the urine
Expressions
Metrorrhagia
hemorrhage in the uterus
Expressions
Enterorrhagia
intestinal hemorrhage
Expressions
Hematochezia
- bloody feces (associated with lower GI tract bleeding)
Expressions
Melaena
bloody feces because of enterorhagia
Expressions
Hemopericardium, -thorax, -peritoneum
Heart, thorax, abdomen
Expressions
(haemaspiratio
- inhalation of blood)

Haemorrhages in the pelvis of the kidney, swine

Hemorrhage in the Bowman’s capsule

Heamorrhage in the spleen
Forms of hemorrhage
• By origin
– hemorrhage by rhexis
– rhexis = breaking forth
- Vessel wall continuity defect
- Physically disrupted vessel

Pars esophagica ulceration, stomach, pig. Rhectic hemorrhage.

Ascending pyelonephritis, rhectic hemorrhage, dog
Forms of haemorrhages
By origin
– hemorrhage by diapedesis
• Small defects in otherwise intact blood vessels
• Increased vessel wall permeability (RBCs in small number)
• Decreased coagulability (thrombocytopenias)
• Clotting factor deficiencies (von Willebrand’s disease)
• Acquired coagulation disorders
– Vitamine K deficiency, warfarin toxicosis, liver disease
• DIC
Forms of Haemorrhage
By appearance
From small to large
– Petechial (vibex) < EcchymoticSuffusion < Hematoma < Apoplexy

Petechiae, gut, horse

Ecchymosis, dog

Purpura

Petechiae and ecchymoses, epicardium

Petechiae, meninges, swine

Elongated hemorrhages (vibex), muscle

Intramuscular haemorrhages, poultry

Suffusions, mesentery

Haematoma, liver

Sublingual haematoma, dog

Perirenal haematoma, swine

Perirenal haematoma, cat

Apoplexy, cat

Petechial bleeding, Thymus cattle BNP

Old haematoma liver

After bleeding
What are the Signs of hemorrhages
- Hemorrhagic infiltration of lymph nodes
- Brownish red color from haemoglobin
- Degradation of haemoglobin

Haemorrhagic infiltration
of lymph nodes, large intestine, swine

Pseudomelanosis, salmonellosis, swine
Factors predisposing to thrombosis (Virchow’s triad)
- Alterations in the vascular endothelium
- Alterations in blood flow
- Alterations in blood constituents = HYPERCOAGULOBILITY

Thrombosis of the arteria iliaca externa, horse

Umbilical vein foal
Red thrombus characteristics
• Like clotting
• Stasis!
• Cellular damage (RBCs)
• Usually together with white thrombus
• BUT stasis for any reason
– Heart failure – all over
– Right side failure
• Truncus pulmonalis, lung
– Hypoalbuminaemia
• cachexia, liver or kidney failure
What is the Mechanism of Stasis
– Plasma leakage
– Higher viscosity
– Higher resistance in the lumen
– Slowing down of the blood flow

Stasis

Recanalisation of a thrombus, submucosa, horse
Thrombosis in species
• Horse
– a. mesenterialis cran., abdominal aorta
Thrombosis in species
• Cattle
– in the wall of the uterus (septic metritis)
Thrombosis in species • Human!
• Cat
– abdominal aorta
Thrombosis in species
• Other species (swine, cattle, dog)
endocarditis

Vegetative valvular endocarditis
heart
white thrombus
(Endocarditis thrombo-ulcerosa)
What is EMBOLISM
Embolus
– a solid mass or gas bubble of either internal or external origin carried by the bloodstream sticks in a narrower blood vessel
– free-floating foreign material within the blood
• Embolism: transport process
Types of EMBOLI
Thrombus or a part of it ( - thombo-embolism)
– emboli derived from fragments of a thrombus
Cells or cell groups
Air or gas bubble
Fat droplets–from bone marrow after fracture
Parasites–Dirofilaria, flukes
Aggregates of bacteria,fungi
Tumor cells
Tissue fragments(skin)
Solid foreign material

Air embolism, dog
Cause of embolism
- Trauma
- Sudden movements
- Forced abdominal pressure
- Coughing
- Inflammation, malignant tumor
- Iatrogen cause
Outcome of embolism
Local: infarct
– Venous – pulmonary circulation
– Arterious – smaller artery downstream
Metastasis of pathogens, spreading of pathogenic processes
Sudden death (lung, brain)

Anaemic infarcts, kidney, swine
What are Regressive changes
Edema, disturbances in water balance of cells and the organism, disturbances in fat metabolism
Location of water intracellular is called?
- Intercellular (in tissue spaces) = edema
- Transcellular (in the lumen of the organs)
- intestines, body cavities
What regulates the water balance?
-
•Nervous system
- • Hypothalamus
- • Kidney, sweating, respiration, gastric juice
- • Hypothalamus
-
•Hormonal regulation
-
• endocrine glands
- • Hypophysis (vasopressin, aldosterone), thyroid gland (tiroxin)
-
• endocrine glands
-
•Physical-chemical factors
- • maintenance of constant osmotic pressure
What causes Increased Retention of water
INCREASED
• Hydrostatic pressure – venous congestion
• Colloid osmotic pressure of the interstitium
• Vascular permeability
What causes Decreased Retention of water
DECREASED
• Colloid osmotic pressure of the plasma
- *• Tissue tension** - starvation
- *• Capacity of the lymph vessels**
- Electrolite imbalance – kidney failure
Nomenclature of the water balance disturbances
• Hyperhydria
• Anasarca
Fluid accumulation in the subcutaneous tissue
Nomenclature of the water balance disturbances
• Hyperhydria
• Hydrops
•transudate – exudate
•hydrops haemorrhagicus acutus
- hydrops adiposus
- hydrops chylosus
Nomenclature of the disturbances
• Hyperhydria
•Ascites
Fluid accumulation in the abdomen
Offen cause of cirrhose
Nomenclature of the disturbances
- Hyperhydria
- Hydrothorax
•Hydropericardium
Water accumulation in the thorax, heart pericardium
Nomenclature of the disturbances
• Hyperhydria
• Edema
– intercellular water accumulation

HYDROTHORAX

Hydrops chylosus

Disse space

Fluid in the transcellular space
Classification of the edema
-
Time of the appearance
- Oe. congenitale or aquisita
-
Pathogenesis
-
Oe. stagnationis
- cardiale
-
Oe. dysoricum
- • inflammatorium, toxicum, allergicum, angioneuroticum
- • Oe. ex hypoproteinaemia (hydraemia)
- • cachecticum, renale (oedema ex vacuo)
- • Oe. lymphangioticum
- • Oe. hormonale - myxoedema
-
Oe. stagnationis
Cell swelling

Functional disturbances of the sodium pump result in water influx

Vacuolar degeneration

Hydropic degeneration

Reticulated degeneration

Balloning degeneration

Balloning degeneration

Vesicular degeneration
Water disturbances Causes in cell
- Hypoxia
- autointoxication
- burns, frostbites
- extended tissue necrosis
- acidosis, alkalosis
- infectious diseases
- exogenous toxins
- Hypoproteinemia
Where do we find Simple fats DEPOT
•
- Subcutaneous fat,
- kidney,
- under serous membranes,
- bonemarrow
Pathology of Disturbances in water balance of cells
- Organs are swollen, enlarged, and pale
- Dried cut surface
- Epithelial layers such as skin and mucosal membranes can be dry or jelly like
Staining methods of FATS
• Physical
• Sudan III, scarlet red
- Sudan black, osmic acid
- Oil-red-O
• Chemical
• Nile blue
- PAS
- Schultz method (cholesterol)

Physiological fatty infiltration

Centrilobular fatty infiltration

Centrilobular fatty infiltration

Diffuse pathological fatty infiltration

Diffuse pathological fatty infiltration

Nutmeg pattern fatty infiltration

Pathological simple fatty infiltration

Pathological necrobiotic fatty infiltration
LOCAL Lipoidoses
- Cholesteatoma in the choroid plexus
- On the pleura
- Atherosclerosis
Systemic LIPIDOSES
•Hereditary, congenital
•Sphyngomyelin, gangliosid, kerazine

Lipidoses
Demonstration of glycogen
• Stainings
– PAS (diastase controll)
– Lugol’s solution (brown)
– Best’s carmine (red)

Best’s carmine (red) staining of glycogen
Regulation of glucose metabolism
1) glucose production of the liver (GNG, GGL)
2) glucose uptake of the peripheries (skeletal myocytes, adipocytes)
3) insulin & antagonists (glucagon, STH etc.)

Function of insulin
- Promotes fuel storage after a meal
- Promote growth
Metabolic Pathway affected by INSULIN
- Stimulates glucose storage as glycogen (muscle, liver)
- Stimulates FA synthesis and storage after a high-carbohydrate meal
- Stimulates amino acids uptake and protein synthesis
Function of GLUCAGON
• Mobilizes fuels
• Maintains blood glucose levels during fasting
- Activates gluconeogenesis and glycogenolysis (liver) during fasting
- Activates FA release from adipose tissue
Increased glycogen production or/and accumulation
Overfeeding
Increased activity
Glycogen storage diseases
Glycogen storage disease
Species
Horses, cattle, sheep, dogs, and cats
Name a Glycogen Storage Disease
Gierke’s disease
Less glycogene
• Decreased production – toxical chemicals
– bacterial toxin (??)
– mycotoxins
• Increased mobilization – starvation
What is DIABETES MELLITUS
Cluster of metabolic disorders associated with hyperglycemia.
Permanent hyperglycaemia results in secondary lesions in different organ systems.
Major types of DIABETES
Human
Type I – decreased insulin production due to ß-cell damage
Type II – Insulin-resistance of the peripheries (rel. ins. deff.)
Which type of Diabetes show KETOACIDOSIS
Type I - insulin dependent
Which type of DIABETES are most common in Cats?
TYPE II
Which type of DIABETES are most common in Dogs?
TYPE I
Consequences of DM
Attributed to persistent hyperglycemia and…
• glucose concentration of body fluids and excretes
Polyuria & polydipsia
Emphysematous cystitis (dogs, cats)
Glycogen accumulation in the kidney
Mitotic activity of different cells
- Stem cells (multipotent umbilical stem cells)
-
Labile cells (surface epithelial cells)
- vegetative intermitotic
-
Stabile cells (hepatocytes, renal tubular epithelial cells)
- reverzible postmitotic
-
Permanent cells (nerve cells, striatedmuscle cells)
- fix postmitoticus

Microglial cells

Oligodendroglia, oligocytes
Mononuclear-phagocyta system (MPS)
- Part of the immune system
- Proliferate
-
Clear
- removal, absorption
- phagocytosis (pathogens, destruction of RBCs)
- Produce antibody
What are the different phagocytes
- microphages (granulocytes)
- macrophages
Direct forms of repair
-
Hypotypia
- Original cells, but not the original structure
-
Heteromorphosis
- Instead of original cells other (not connective tissue) type of cells
-
Hyperregeneration, hypermorphosis
- Fill the area, but continue proliferation
-
Repair
- Organisation, Demarcation
Indirect forms of repair
• Accommodation (adaptation) after irrevocable, permanent dysfunction
- Atrophy
- Hypertrophy (increase in size)
- Hyperplasia (increase in number)
- Metaplasia (change in the tissue type)
-
Transformation
- certain changes in internal architecture
What is Metaplasia
-
Special case of defective healing
- One type of differentiated tissue is replaced by another type of differentiated tissue
- Limited possibility of changing
-
Only two types of tissue
- – epithelial tissue to epithelial tissue
- – connective tissue to connective tissue
- NO OTHER POSSIBILITIES!
What is indirect metaplasia
– multipotent cells replace the degenerated tissue
– differentiate in a different way
(columnar epithelium simple epithelium = basal cell metaplasia)
– prosoplasia (more differentiated)
– anaplasia (less differentiated)
Causes of metaplasia
- every kind of cell damage, but…
- …presence of certain conditions
– vitamin A deficiency in poultry
– irritation of the mucosal membranes
by external factors or chronic inflammation
– F-2 toxins in the uterus
– bone tissue formation in a wound
(ovariectomy, chronic hernia, hematoma)
– ossification of the left atrium

Metaplasia of laryngeal respiratory epithelium
The chronic irritation has led to an exchanging of one type of epithelium (the normal respiratory epithelium at the right) for more resilient squamous epithelium (left).

Metaplasia of esophageal squamous mucosa to gastric type columnar mucosa at the left – Barrett’s oesophagus (human)

Mesenchymal metaplasia (abdominal hernia)
What is Pseudometaplasia
- appearences mimicking metaplasia
- different kinds of tissue in a certain place
- originating from choristia
– tonsils–> cartilage
– gastric mucosal tissue—> oesophagus islets
– lung –> kidney tissue
– spinal cord —> some portions of intestines
– simple epithelium of vagina —> columnar ep
What is Allomorphia, dismorphia
• change in shape, but not in type
• reversible
What is Atrophy
Decrease of the size of an organ or cell by reduction in cell size and/or reduction in cell numbers
What is • Hypoplasia
• Failure of normal development of an organ: developmental anomaly
What is Involution
• „Physiological atrophy”
– response to the decreased requirement of the body for the function of a particular cell or organ

Unilateral kidney hypoplasia, cat

Muscular hypoplasia, pig
What are the forms of ATROPHY
• Physiological - pathological
- Simple – degenerative
- Reversible – irreversible
- Regional – complete
• Numeric atrophy
Examples of involutions
Involution (physiological atrophy)
• Embryo or fetus
– Müllerian/Wolffian duct system
• Neonate
– Ductus arteriosus
• Earlyadult
– Thymus
• Adult female
– Cyclic changes in the endometrium
• Old age
– Endometrium, testicles, bone, cerebrum etc.
Pathological atrophy
-
Decreased function – „disuse”
- Muscle atrophy in fractured limbs
-
Loss of innervation
- Injury, inflammation, tumors of nerves etc.
-
Pressure atrophy
- Internal= Tumors - Parasites - CSF-accumulation
- External = „Bed sores”
-
Lack of nutrient supply
- Cachexia
-
Blood supply distrubances
- Thrombosis
-
Disturbances of endocrine stimulation
- Skin atrophy in Cushing’s disease
-
Atrophy due to drug application
- Topical steroids

Cysticercus cysts, brain, monkey

Cysticercus tenuicollis cyst, liver, pig

Atrophy of the cerebral cortex and cerebellar hypoplasia, calf

Urolithiasis in the kidney calyces, cattle

Cachexia, bone marrow, cattle
The atrophied tissue is replaced by another (e. q. connective or fatty) tissue is called?
• muscular pseudohypertrophy

Muscular pseudohypertrophy, horse; cattle